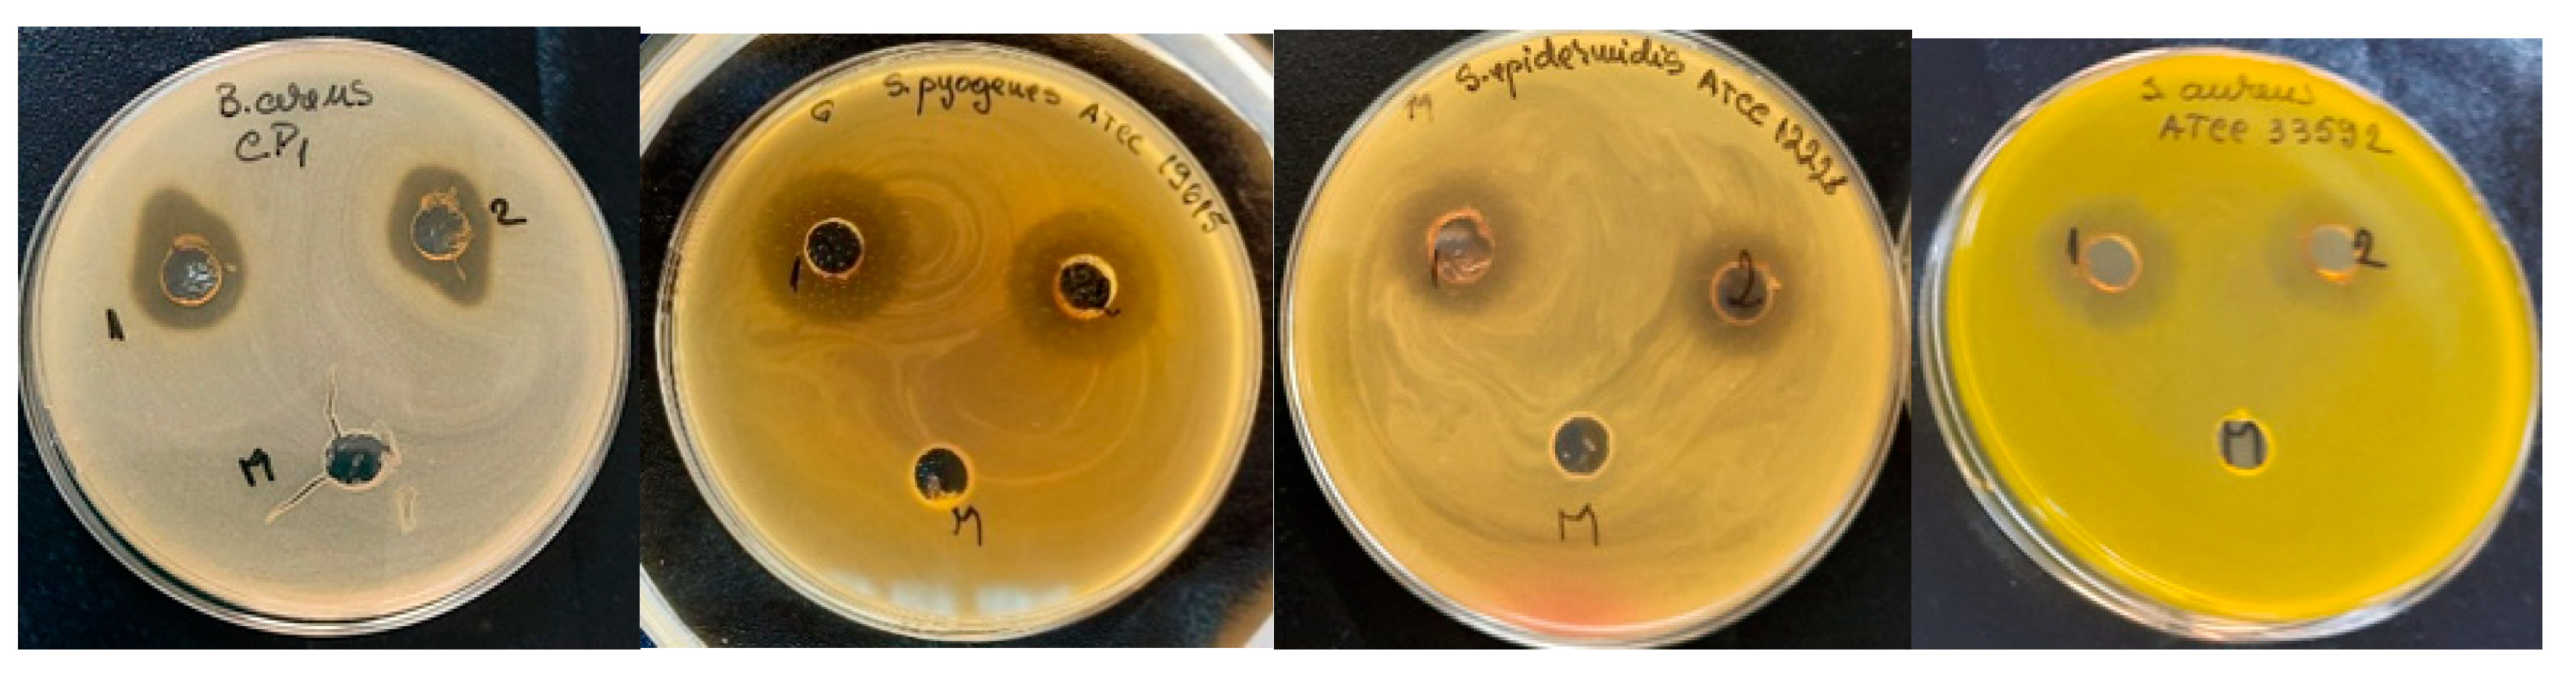
Applmicrobiol 02 00016 g001

Biochemical Profile and Antimicrobial Activity of an Herbal-Based Formula and Its Potential Application in Cosmetic Industry
Abstract
:1. Introduction
2. Materials and Methods
2.1. Preparation of the Bioactive Solution
2.2. Biochemical Profile
2.2.1. Spectrophotometric Analysis of Phenolic Compounds
2.2.2. Spectrophotometric Analysis of Triterpenic Acids
2.2.3. Quantitative Analysis by High-Performance Liquid Chromatography (HPLC)
2.2.4. Antioxidant Activity
2.3. Pharmacologic Activity
2.3.1. Irritant Potential
2.3.2. Antimicrobial Effect
Tested Microorganisms
Testing the Inhibitory Activity on Pathogenic Microorganisms
3. Results
3.1. Biochemical Profile
3.1.1. Total Polyphenols and Triterpenes
3.1.2. Polyphenol Carboxylic Acids
3.1.3. Antioxidant Activity
3.2. Pharmacologic Activity
3.2.1. Irritant Potential
3.2.2. Antimicrobial Effect
4. Conclusions
Author Contributions
Funding
Institutional Review Board Statement
Informed Consent Statement
Conflicts of Interest
References
- Mazzei, R.; Leonti, M.; Spadafora, S.; Patitucci, A.; Tagarelli, G. A review of the antimicrobial potential of herbal drugs used in popular Italian medicine (1850s–1950s) to treat bacterial skin diseases. J. Ethnopharmacol. 2020, 250, 112443. [Google Scholar] [CrossRef] [PubMed]
- Guglielmi, P.; Pontecorvi, V.; Rotondi, G. Natural compounds and extracts as novel antimicrobial agents. Expert Opin. Ther. Pat. 2020, 30, 949–962. [Google Scholar] [CrossRef]
- Ayaz, M.; Ullah, F.; Sadiq, A.; Ullah, F.; Ovais, M.; Ahmed, J.; Devkota, H.P. Synergistic interactions of phytochemicals with antimicrobial agents: Potential strategy to counteract drug resistance. Chem. Biol. Interact. 2019, 308, 294–303. [Google Scholar] [CrossRef]
- Enioutina, E.Y.; Teng, L.; Fateeva, T.V.; Brown, J.C.S.; Job, K.M.; Bortnikova, V.V.; Krepkova, L.V.; Gubarev, M.I.; Sherwin, C.M.T. Phytotherapy as an alternative to conventional antimicrobials: Combating microbial resistance. Expert Rev. Clin. Pharmacol. 2017, 10, 1203–1214. [Google Scholar] [CrossRef] [PubMed]
- Pisoschi, A.M.; Pop, A.; Georgescu, C.; Turcuş, V.; Olah, N.K.; Mathe, E. An overview of natural antimicrobials role in food. Eur. J. Med. Chem. 2018, 143, 922–935. [Google Scholar] [CrossRef]
- Amparo, T.R.; Seibert, J.B.; Vieira, P.M.A.; Teixeira, L.F.M.; Santos, O.D.H.D.; de Souza, G.H.B. Herbal medicines to the treatment of skin and soft tissue infections: Advantages of the multi-targets action. Phytother. Res. 2020, 34, 94–103. [Google Scholar] [CrossRef]
- Verkaik, M.J.; Busscher, H.J.; Jager, D.; Slomp, A.M.; Abbas, F.; van der Mei, H.C. Efficacy of natural antimicrobials in toothpaste formulations against oral biofilms in vitro. J. Dent. 2011, 39, 218–224. [Google Scholar] [CrossRef] [Green Version]
- Zhongpeng, Y.; Ling, Z. Advance in herbal medicine applied to intracanal antisepsis. Hua Xi Kou Qiang Yi Xue Za Zhi 2014, 32, 621–624. [Google Scholar]
- Soltani, S.; Shakeri, A.; Iranshahi, M.; Boozari, M. A Review of the Phytochemistry and Antimicrobial Properties of Origanum vulgare L. and Subspecies. Iran. J. Pharm. Res. 2021, 20, 268–285. [Google Scholar] [PubMed]
- Kolodziej, H. Aqueous ethanolic extract of the roots of Pelargonium sidoides—New scientific evidence for an old anti-infective phytopharmaceutical. Planta Med. 2008, 74, 661–666. [Google Scholar] [CrossRef]
- Salehi, B.; Selamoglu, Z.; Sevindik, M.; Fahmy, N.M.; Al-Sayed, E.; El-Shazly, M.; Csupor-Löffler, B.; Yazdi, S.E.; Sharifi-Rad, J.; Arserim-Uçar, D.K.; et al. Achillea spp.: A comprehensive review on its ethnobotany, phytochemistry, phytopharmacology and industrial applications. Cell. Mol. Biol. 2020, 66, 78–103. [Google Scholar] [CrossRef]
- Radusiene, J.; Gudaityte, O. Distribution of proazulenes in Achillea millefoliums wild populations in relation to phytosociological dependence and morphological characters. Plant Genet. Resour. 2005, 3, 136–143. [Google Scholar] [CrossRef]
- Strzępek-Gomółka, M.; Gaweł-Bęben, K.; Kukula-Koch, W. Achillea Species as Sources of Active Phytochemicals for Dermatological and Cosmetic Applications. Oxid. Med. Cell. Longev. 2021, 2021, 6643827. [Google Scholar] [CrossRef]
- Zengin, G.; Aktumsek, A.; Ceylan, R.; Uysal, S.; Mocan, A.; Guler, G.O.; Mahomoodally, M.F.; Glamočlija, J.; Ćirić, A.; Soković, M.; et al. Shedding light on the biological and chemical fingerprints of three Achillea species (A. biebersteinii, A. millefolium and A. teretifolia). Food Funct. 2017, 8, 1152–1165. [Google Scholar] [CrossRef] [PubMed]
- Anonymus. The Wealth of India, Publication & Information Directorate; Council of Scientific and Industrial Research: New Delhi, India, 1962; p. 186. [Google Scholar]
- Güvensen, N.C.; Keskin, D.; Yildiz, K. Comparision of antimicrobial activity of different extracts of Silene coronaria (Desr.) Clairv. ex Rchb. and Silene denizliensis Aytaç. grown in Turkey. Glob. J. Res. Med. Plants Indig. Med. 2016, 5, 286–291. [Google Scholar]
- Ai-Turki, A.I.; Ei-Ziney, M.G.; Abdel-Salam, A.M. Chemical and anti-bacterial characterization of aqueous extracts of oregano, marjoram, sage and licorice and their application in milk and labneh. J. Food Agric. Environ. 2008, 6, 39–44. [Google Scholar]
- Babacan, O.; Cengiz, S.; Akan, M. Detection of antibacterial effect of oregano plant on various Salmonella serotypes. Ank. Univ. Vet. Fak. Derg. 2012, 59, 103–106. [Google Scholar]
- Brand-Williams, W.; Cuvelier, M.E.; Berset, C. Use of a free radical method to evaluate antioxidant activity. LWT Food Sci. Technol. 1995, 28, 25–30. [Google Scholar] [CrossRef]
- Oniga, I.; Pușcaș, C.; Silaghi-Dumitrescu, R.; Olah, N.K.; Sevastre, B.; Marica, R.; Marcus, I.; Sevastre-Berghian, A.C.; Benedec, D.; Pop, C.E.; et al. Origanum vulgare ssp. vulgare: Chemical Composition and Biological Studies. Molecules 2018, 23, 2077. [Google Scholar] [CrossRef] [PubMed] [Green Version]
- Apel, L.; Lorenz, P.; Urban, S.; Sauer, S.; Spring, O.; Stintzing, F.C.; Kammerer, D.R. Phytochemical characterization of different yarrow species (Achillea sp.) and investigations into their antimicrobial activity. Z. Naturforsch C J. Biosci. 2020, 76, 55–65. [Google Scholar] [CrossRef]
- Benedec, D.; Hanganu, D.; Oniga, I.; Filip, L.; Bischin, C.; Silaghi-Dumitrescu, R.; Tiperciuc, B.; Vlase, L. Achillea schurii Flowers: Chemical, Antioxidant, and Antimicrobial Investigations. Molecules 2016, 21, 1050. [Google Scholar] [CrossRef] [PubMed] [Green Version]
- Ferry, S.; Darbour, N. Phenolic acids of three species of Lychnis: Lychnis alba Mill., Lychnis flos-cuculi L.; Lychnis githago Scop. Plant. Med. Phytother. 1979, 13, 192–198. [Google Scholar]
- Guz, L.; Adaszek, Ł.; Wawrzykowski, J.; Ziętek, J.; Winiarczyk, S. In vitro antioxidant and antibabesial activities of the extracts of Achillea millefolium. Pol. J. Vet. Sci. 2019, 22, 369–376. [Google Scholar]
- Halla, N.; Fernandes, I.P.; Heleno, S.A.; Costa, P.; Boucherit-Otmani, Z.; Boucherit, K.; Rodrigues, A.E.; Ferreira, I.C.; Barreiro, M.F. Cosmetics Preservation: A Review on Present Strategies. Molecules 2018, 23, 1571. [Google Scholar] [CrossRef] [Green Version]
- Di Domenico, E.G.; Cavallo, I.; Capitanio, B.; Ascenzioni, F.; Pimpinelli, F.; Morrone, A.; Ensoli, F. Staphylococcus aureus and the Cutaneous Microbiota Biofilms in the Pathogenesis of Atopic Dermatitis. Microorganisms 2019, 7, 301. [Google Scholar] [CrossRef] [Green Version]
- Liu, Q.; Mazhar, M.; Miller, L.S. Immune and Inflammatory Reponses to Staphylococcus aureus Skin Infections. Curr. Dermatol. Rep. 2018, 7, 338–349. [Google Scholar] [CrossRef] [PubMed]
- Purcaru, T.; Diguta, C.F.; Matei, F. Antimicrobial potential of Romanian spontaneous flora—A minireview. Sci. Pap. Ser. B Hortic. 2018, LXII, 667–680. [Google Scholar]
- Baris, D.; Kizil, M.; Aytekin, C.; Kizil, G.; Yavuz, M.; Ceken, B.; Ertekin, A.S. In vitro antimicrobial and antioxidant activity of ethanol extract of three Hypericum and three Achillea species from Turkey. Int. J. Food Prop. 2011, 14, 339–355. [Google Scholar] [CrossRef]
- Romero, C.D.; Chopin, S.F.; Buck, G.; Martinez, E.; Garcia, M.; Bixby, L. Antibacterial properties of common herbal remedies of the southwest. J. Ethnopharm. 2005, 99, 253–257. [Google Scholar] [CrossRef]
- Jianu, C.; Mişcă, C.; Muntean, S.G.; Gruia, A.T. Composition, antioxidant and antimicrobial activity of the essential oil of Achillea collina Becker growing wild in western Romania. Hem. Ind. 2015, 69, 381–386. [Google Scholar] [CrossRef]
- Jianu, C.; Golet, I.; Misca, C.; Jianu, A.M.; Pop, G.; Gruia, A.T. Antimicrobial properties and chemical composition of essential oils isolated from six medicinal plants grown in Romania against foodborne pathogens. Rev. Chim. 2016, 67, 1056–1061. [Google Scholar]
- Benedec, D.; Hanganu, D.; Oniga, I.; Tiperciuc, B.; Olah, N.K.; Raita, O.; Bischin, C.; Silaghi-Dumitrescu, R.; Vlase, L. Assessment of rosmarinic acid content in six Lamiaceae species extracts and their antioxidant and antimicrobial potential. Pak. J. Pharm. Sci. 2015, 28, 2297–2303. [Google Scholar] [PubMed]
- Maliński, M.P.; Michalska, A.D.; Tomczykowa, M.; Tomczyk, M.; Thiem, B. Ragged Robin (Lychnis flos-cuculi)—A plant with potential medicinal value. Rev. Bras. Farmacog. 2014, 24, 722–730. [Google Scholar] [CrossRef] [Green Version]
- Mamadalieva, N.Z. Phytoecdysteroids from Silene plants: Distribution, diversity and biological (antitumour, antibacterial and antioxidant) activities. Bol. Latinoam. Caribe. Plant Med. Aromat. 2012, 11, 474–497. [Google Scholar]
| No. | Microorganisms | Origin |
|---|---|---|
| Bacterii | ||
| 1. | Bacillus cereus CP1 | UASMVB collection |
| 2. | Kocuria kristinae | UASMVB collection |
| 3. | Escherichia coli ATCC * 8739 | ATCC |
| 4. | Listeria ivanovii ATCC 19119 | ATCC |
| 5. | Listeria monocytogens ATCC 7644 | ATCC |
| 6. | Proteus vulgarius ATCC 13315 | ATCC |
| 7. | Pseudomonas aeruginosa ATCC 9027 | ATCC |
| 8. | Salmonella enterica Typhimurium ATCC 14028 | ATCC |
| 9. | Staphylococcus aureus ATCC6538 | ATCC |
| 10. | S. aureus ATCC 33592 MRSA ** | ATCC |
| 11. | S. epidermidis ATCC12228 | ATCC |
| 12. | S. epidermidis ATCC 51625 MRSE ** | ATCC |
| 13. | Serratia marescens ATCC 14756 | ATCC |
| 14. | Streptococcus pyogens ATCC 19615 | ATCC |
| 15. | Enterococcus faecalis ATCC 29212 | ATCC |
| Fungi | ||
| 16. | Candida albicans ATCC 10231 | ATCC |
| 17. | C. parapsilosis ATCC20019 | ATCC |
| 18. | C. glabrata ATCC 2001 | ATCC |
| 19. | C. tropicalis ATCC 44508 | ATCC |
| 20. | C. guilliermondii MI 40 | UASMVB collection |
| 21. | C. krusei 2016 MI 41 | UASMVB collection |
| 22. | Aspergillus carbonarius | UASMVB collection |
| 23. | Aspergillus niger | UASMVB collection |
| 24. | Aspergillus flavus | UASMVB collection |
| Sample | Total Polyphenols Expressed as Gallic Acid (%) | Total Triterpenes Expressed as Ursolic Acid (%) |
|---|---|---|
| Raw material Origanum vulgare | 6.070 | 1.053 |
| Raw material Lychnis coronaria | 0.540 | 2.792 |
| Raw material Achillea millefolium | 1.098 | 1.051 |
| Herbal formula | 0.916 | 0.478 |
| Polyphenol Carboxylic Acid Content (HPLC) | mg/100 mL: |
|---|---|
| -Chlorogenic acid: | 10.58 |
| -Caffeic acid: | 11.66 |
| -Rosmarinic acid: | 19.33 |
| -Gallic acid: | 0.68 |
| Total: | 42.26 |
| Sample * | Average OD | Stdev | Relative Viability | Conclusion |
|---|---|---|---|---|
| Positive control (DPBS) | 1.1643 ± 0.125 | - | ||
| Negative control (SDS) | 0.0875 ± 0.240 | 0.0016 | 8.86 | |
| Formula | 1.0906 * ± 0.135 | 0.7890 | 110.88 | Nonirritant (NI) |
| Nr. crt. | Microorganism | Inhibition Diameter (mm) | Antibacterial Activity |
|---|---|---|---|
| 1. | Bacillus cereus CP1 | 17 ± 0.25 | ++ |
| 2. | Kocuria kristinae | 18 ± 0.15 | ++ |
| 3. | Escherichia coli ATCC 8739 | 7 ± 1.2 | + |
| 4. | Listeria ivanovii ATCC 19119 | 4 ± 1.4 | + |
| 5. | Listeria monocytogens ATCC 7644 | - | - |
| 6. | Proteus vulgarius ATCC 13315 | - | - |
| 7. | Pseudomonas aeruginosa ATCC 9027 | 12 ± 0.25 | ++ |
| 8. | Salmonella enterica Typhimurium ATCC 14028 | 16 ± 0.34 | ++ |
| 9. | Staphylococcus aureus ATCC6538 | 18 ± 0.25 | ++ |
| 10. | S. aureus ATCC33592 MRSA | 19.7 ± 0.14 | ++ |
| 11. | S. epidermidis ATCC 51625 MRSE | 21 ± 0.15 | +++ |
| 12. | S. epidermidis ATCC12228 | 20 ± 0.17 | ++ |
| 13. | Serratia marescens ATCC 14756 | 28 ± 0.25 | +++ |
| 14. | Streptococcus pyogens ATCC 19615 | 31 ± 0.35 | +++ |
| 15. | Enterococcus faecalis ATCC 29212 | 5 ± 0.10 | + |
Publisher’s Note: MDPI stays neutral with regard to jurisdictional claims in published maps and institutional affiliations. |
© 2022 by the authors. Licensee MDPI, Basel, Switzerland. This article is an open access article distributed under the terms and conditions of the Creative Commons Attribution (CC BY) license (https://creativecommons.org/licenses/by/4.0/).
Share and Cite
Grigore, A.; Pirvu, L.C.; Bejanaru, I.; Neagu, G.; Diguta, C.F.; Glava, L.; Ionita, C.; Matei, F. Biochemical Profile and Antimicrobial Activity of an Herbal-Based Formula and Its Potential Application in Cosmetic Industry. Appl. Microbiol. 2022, 2, 227-236. https://doi.org/10.3390/applmicrobiol2010016
Grigore A, Pirvu LC, Bejanaru I, Neagu G, Diguta CF, Glava L, Ionita C, Matei F. Biochemical Profile and Antimicrobial Activity of an Herbal-Based Formula and Its Potential Application in Cosmetic Industry. Applied Microbiology. 2022; 2(1):227-236. https://doi.org/10.3390/applmicrobiol2010016
Chicago/Turabian StyleGrigore, Alice, Lucia Camelia Pirvu, Ionica Bejanaru, Georgeta Neagu, Camelia Filofteia Diguta, Luciana Glava, Carmen Ionita, and Florentina Matei. 2022. "Biochemical Profile and Antimicrobial Activity of an Herbal-Based Formula and Its Potential Application in Cosmetic Industry" Applied Microbiology 2, no. 1: 227-236. https://doi.org/10.3390/applmicrobiol2010016
APA StyleGrigore, A., Pirvu, L. C., Bejanaru, I., Neagu, G., Diguta, C. F., Glava, L., Ionita, C., & Matei, F. (2022). Biochemical Profile and Antimicrobial Activity of an Herbal-Based Formula and Its Potential Application in Cosmetic Industry. Applied Microbiology, 2(1), 227-236. https://doi.org/10.3390/applmicrobiol2010016






